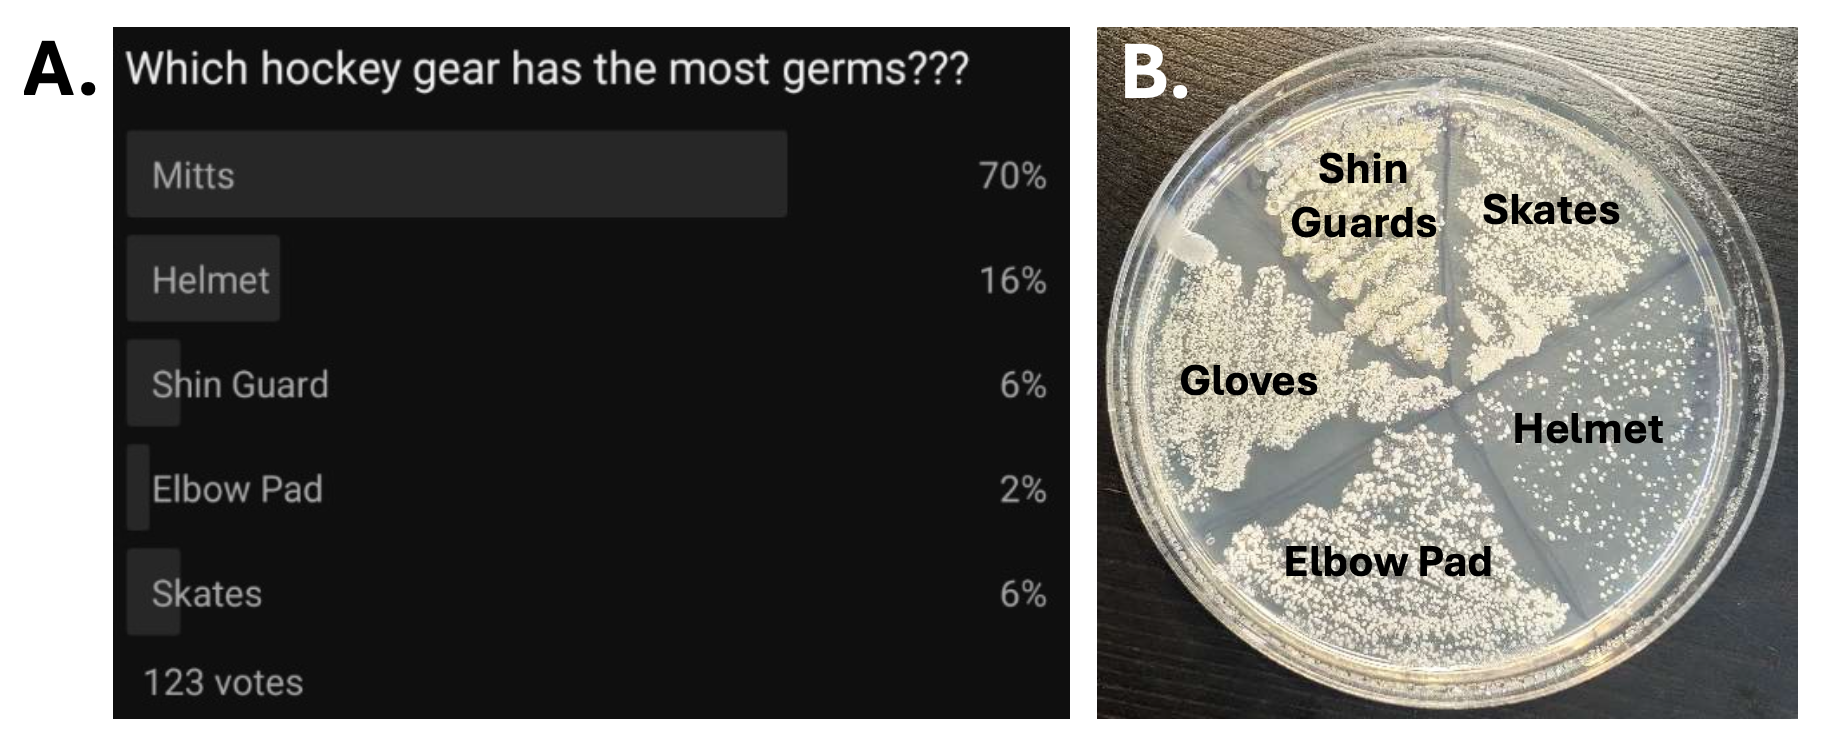
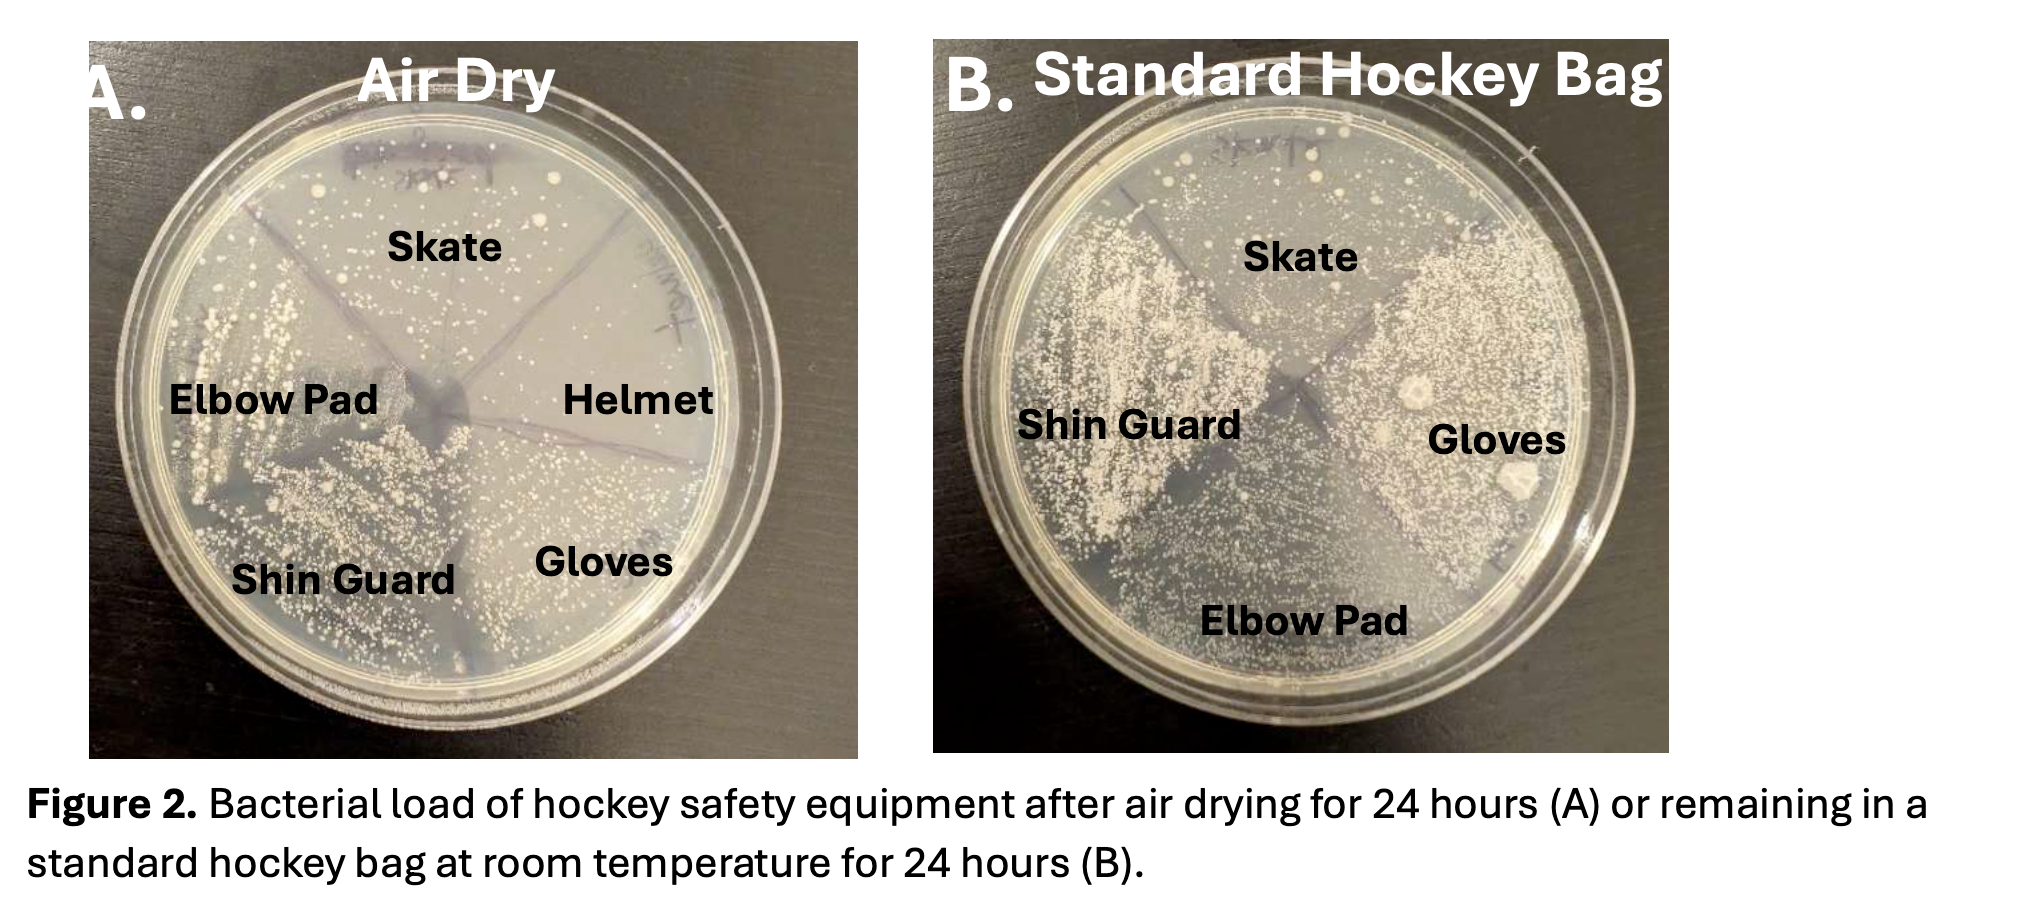
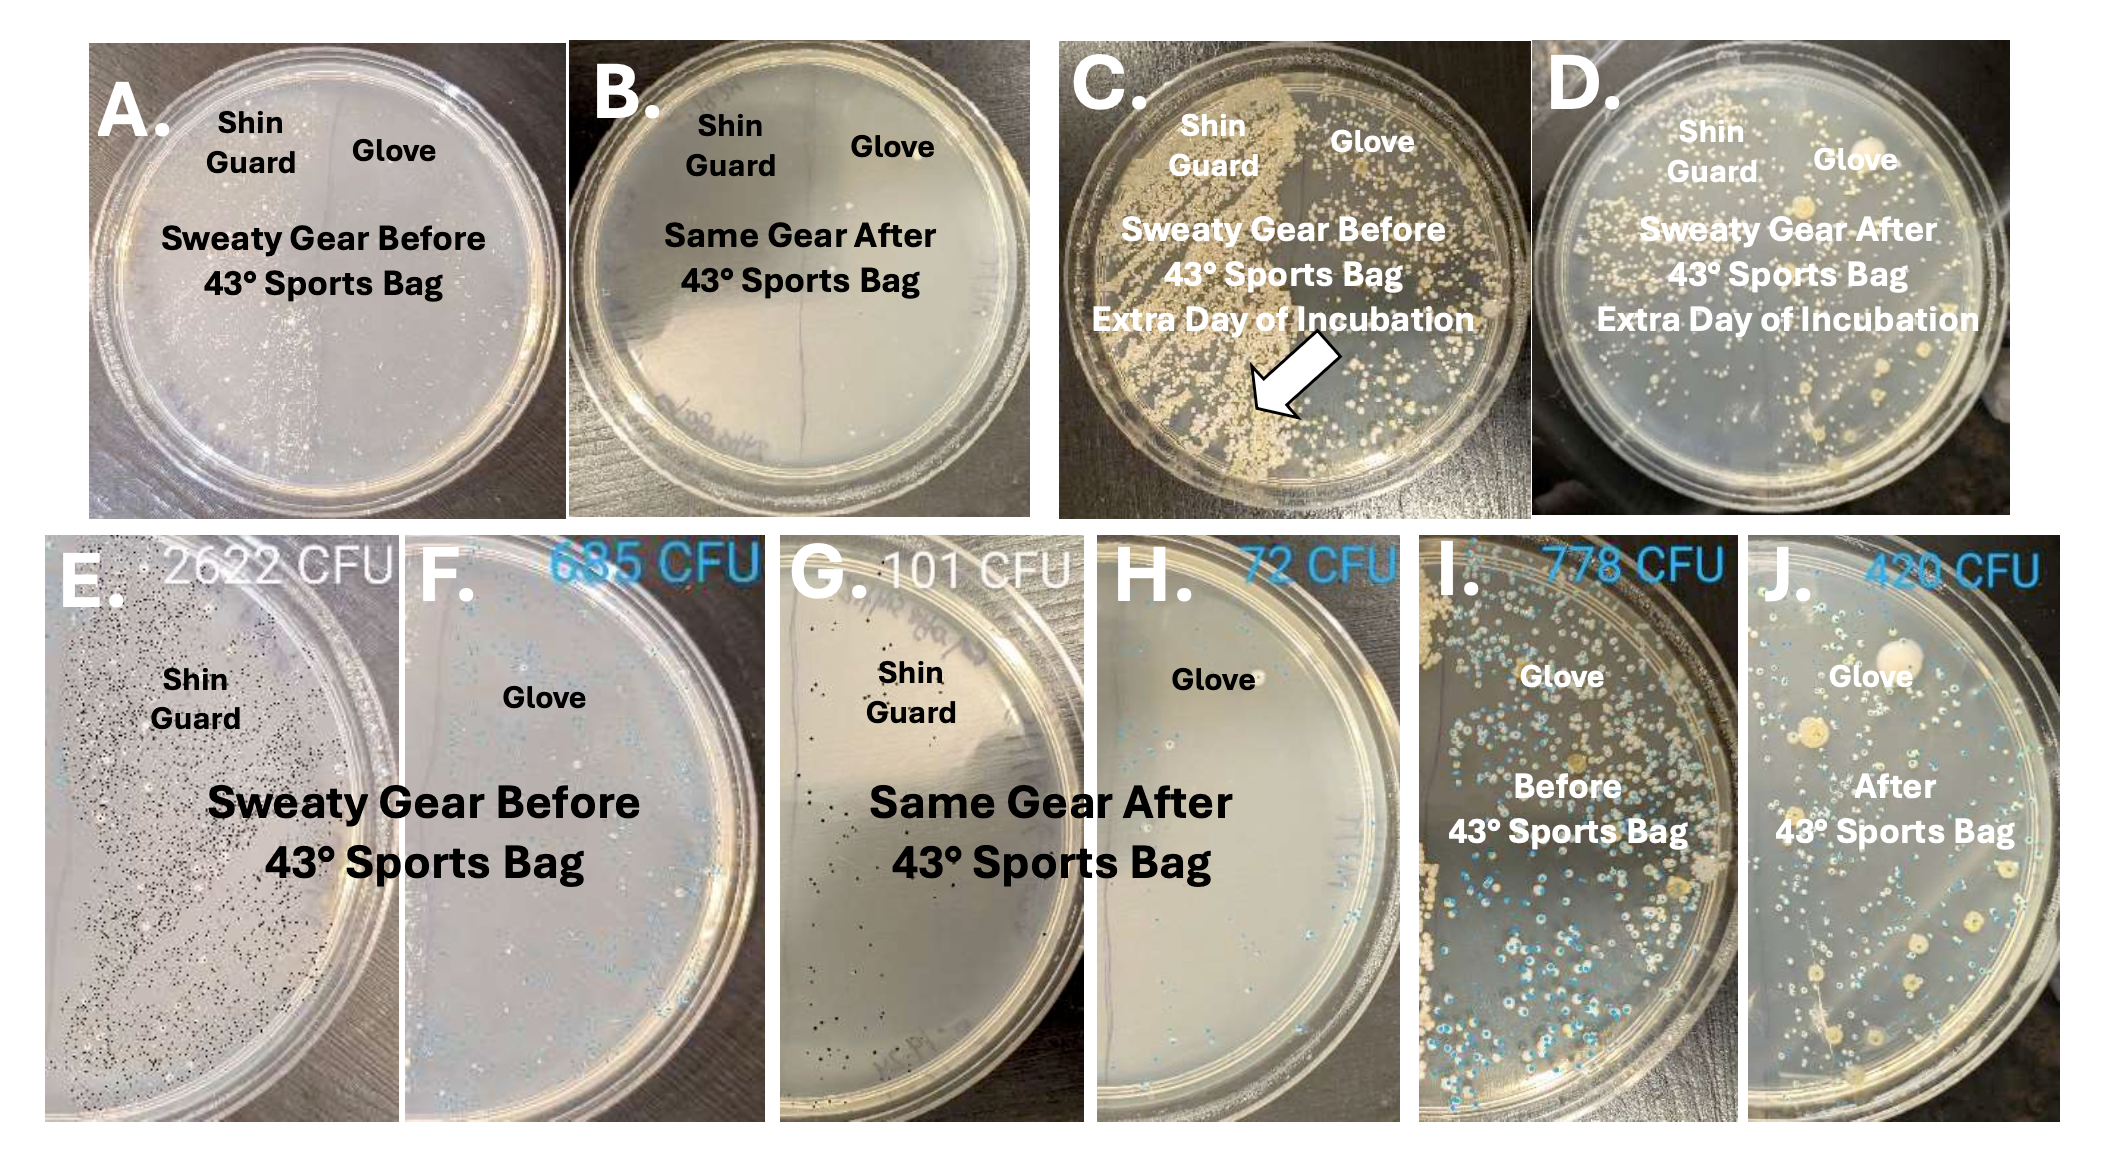

How it works
23+
Years of rigorous testing and Improving
The 43° Hockey Bag uses controlled heat to eliminate odor causing bacteria at the source. Just like the body raises its temperature to fight infection, the bag elevates heat to levels proven to kill bacteria living deep inside your gear. This process thoroughly sanitizes and dries your equipment, leaving it clean, fresh, and ready for your next skate.
US Patent #11,771,191
The Science of Clean Gear
Backed by an independent study. Built for healthier hockey.
Section 1:
The Problem
Bacteria does more than cause odor. It can contribute to skin infections, illness, and long term damage to your equipment. That "hockey" smell is your body’s warning system telling you something is wrong, and most hockey gear is far dirtier than people realize.

Hockey equipment creates the perfect environment for bacteria to grow. Sweat, heat, and moisture become trapped deep inside pads, gloves, and skates. Even when gear feels dry, harmful bacteria can remain.
Traditional solutions like air drying or washing do not fully solve the problem. In some cases, washed gear still contains significant bacterial levels and can take days to fully dry.
Section 2:
The Study
An independent study conducted by David A. Narvaiz, PhD examined bacterial growth in hockey equipment and evaluated how effectively the 43° Sports Temperature Controlled Hockey Bag reduced bacteria compared to traditional cleaning and drying methods.
The study measured bacterial levels on multiple pieces of equipment before and after treatment.

Traditional solutions like air drying or washing do not fully solve the problem. In some cases, washed gear still contains significant bacterial levels and can take days to fully dry.
Section 3:
The Results
The results were clear and consistent.
Up to 96% reduction in odor causing bacteria
Lower bacterial levels than traditionally washed gear
46-89% reduction on gloves, one of the dirtiest pieces of equipment
Gear heated to 60°C or 140°F, a temperature known to kill bacteria
Humidity reduced to approximately 20 percent, where bacteria cannot survive or multiply
Bacteria Growth Before & After 43° Hockey Bag

Section 4:
Why This Matters?
Less bacteria means more than just less odor.
Reducing bacterial exposure helps lower the risk of infections and illness. Healthier players miss fewer practices and games and maintain consistency throughout the season.
Warm, dry gear also performs better. Gloves break in faster. Skates dry fully. Equipment lasts longer and feels better every time you step on the ice.
Better health supports better performance.

Section 5:
The 43° Difference
The 43° Hockey Bag is not a dryer. It is a temperature and humidity controlled sanitizing system designed specifically for hockey equipment. Sanitize, dry, preheat, and always have clean, dry gear that is ready to perform at it's best.
Clean gear starts with science.

FEATURES
Preheat, Sanitize, Dry, and Deodorize
1-2 Hour Heat Cycle
PreGame Warmup - Dry Equipment

The preheat cycle warms skates, softens gloves, and gives gear a fresh feel. Stand out in the locker room with odorless, dry, and warm equipment, perfect for cold rinks, early mornings, and your favorite ODR.

In the initial 60 minutes, the 43° bag surpasses 100º F, hitting its max at 124.5°F in under 2 hours. For your preferred pregame warmth, switch it on 1-2 hours before leaving the rink.
Sanitize and Dry: 12 Hour Heat Cycle
Post Game - Wet Equipment

Leave your heated hockey bag on HOT for 8-14 hours to eliminate bacteria and odor from your pads, leaving them sanitized, dry, and odorless.
Drying time will depend on size of the equipment and how much the user sweats in them.

In 90 minutes, the bag exceeds 43°C (109°F), eliminating odor and harmful bacteria. It stabilizes to combat bacteria, remove sweat residue, and reduce "hockey smell." Cleaned air releases, allowing pads to breathe and dry. After 12 hours, humidity equalizes, completing the sanitization and drying cycle.
Example of A Late Night Mens League Game



